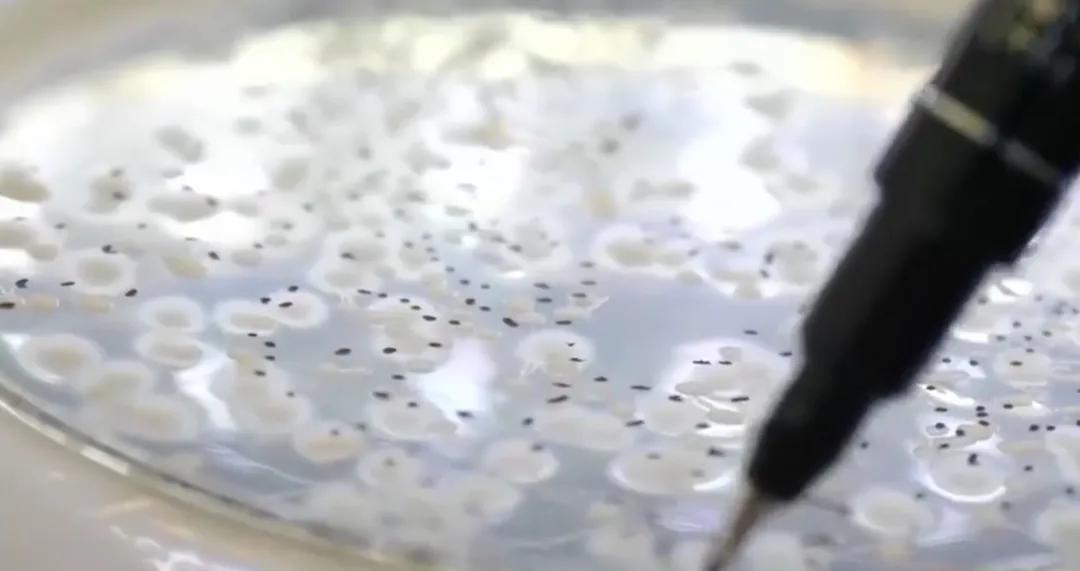
一分钟带你了解对虾肝肠孢虫,对虾肝肠孢虫苗期能看出来吗

各位对虾养殖老板注意了,近期频发的 肝肠孢虫 ,想必大家也都清楚,不少养殖老板因“它”排塘,损失很大!

有几位养殖老板反映 肝肠孢虫 的数量通过PCR检测是惊人的,严重影响虾的消化和吸收,出现 生长缓慢现象,饵料效率差,成虾商品价格低,造成经济损失。

关于诊断对虾是否存在肝肠孢虫寄生,这一点还是比较好判断的:
前期观察对虾是否存在生长缓慢现象,同一池塘中 比较对虾大小 ,如果出现大小不一这种情况,那么需要进一步通过检测来确诊。由于肝肠孢虫虫体较小 ,一般都是采用PCR进行检测。

感染了肝肠孢虫还会出现这种情况:
没有出现太多明显的 死亡 ,尽管虾子比较小,但肠、胃仍然充满着食物, 肝胰腺 略微萎缩,发软, 但 颜色 比较深 ,所以从表面上看起来,虾并没有 明显病症 问题,但就是不长个,偶尔伴随有 白便 。

对虾肝肠胞虫是怎样传播的?
1、从 种苗携带病原垂直传播。
2、被对虾肝肠孢虫 污染 了 养殖池 进行水平传播。
对于肝肠孢虫应该怎么办?
1、养殖朋友从 苗种期 就要做好筛选工作,做好虾苗检测工作,避免购买携带病原的虾苗。
2、做好虾池清淤和调水工作,减少养殖水体有机物的含量,尽可能的 减少 肝肠孢虫形成重复感染的机会。

3、驱虫选择 乐畅 ,因为肝肠孢虫具有一层坚韧的几丁质外壳 ,一般药物很难穿透,而乐畅是从澳大利亚进口的多苞桉树叶中提取的,里面含有丰富的桉树脑;

桉树脑具有良好的 脂溶性 ,易于穿透虫的生物膜结构,从而破坏细胞的完整性,导致虫的机体功能紊乱,让 虫自然死亡 ,从而达到良好的驱虫作用。主要的是不伤虾,不坏水,不会影响摄食,还能促进肠道细胞蠕动,促进摄食。
本文转自“ 水产抗虫联盟 ”微信公众号,想要了解更多养殖资讯可以关注一下!